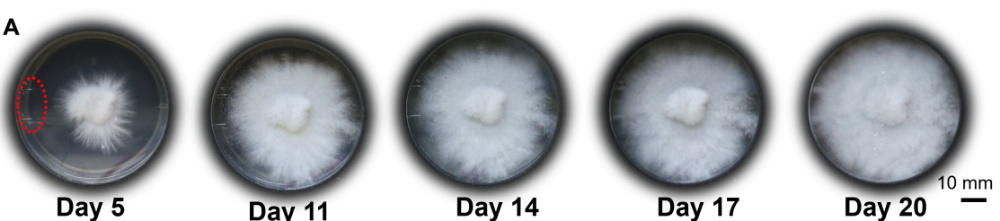

谁说机器人一定由冰冷的“硅基”金属和电路操控?如今,结合生命体与机器人的“生物混合机器人”已成为新的前沿方向。去年,美国康奈尔大学的研究团队带来了一项有趣的突破:他们成功利用餐桌上常见的杏鲍菇,操控两款不同形态的机器人运动。那么,他们究竟如何实现这一奇思妙想的呢?
撰文 | 李勃(陕西省生物农业研究所)
从上世纪80年代风靡至今的日本动漫《机动战士高达》,到近年来震撼全球的好莱坞大片《环太平洋》,操控强大的机甲去战斗,是无数小男孩和“老男孩”的梦想与浪漫。
但你可曾想过,未来的机甲或许不是由冰冷的金属和电路控制的,而是由......蘑菇来指挥?没错,就是那种长在森林里、可以下锅煎炒的蘑菇!

日本馆门前的巨型高达机甲战士成为2025年大阪世博会的金字招牌丨图源:李旻摄

《环太平洋》中守卫香港的中国机甲“赤红暴风”丨图源:官方电影海报

亮相长春航展的中国科幻IP“南天门计划”中的承影机甲丨图源:央视新闻
机甲操控:看似触手可及,实则难度重重
机甲一词,来源于日语中的“メカ”,英语里称为Mecha,通常指科幻作品中由人类操作的大型战斗机器人。在上个世纪,这也许还只是遥不可及的幻想。如今,随着AI和工程技术的迅猛发展,不少机器人已能做出流畅的动作,甚至协助人类完成诸多任务。

宇树科技开发的人形机器人亮相春晚丨图源:央视传媒
当然,要让高达机甲像人一样灵活战斗,依然困难重重。目前的机器人主要由传感器、执行器和负责发出指令的机器神经网络构成,相比经过亿万年进化的生命体,这样的结构还是太过简单。现有传感器的灵敏度虽高,大多却只能检测单一的信号(如压力、光、热、湿度等),难以应对复杂多变的环境。
而动物和人类拥有密度极高的感受器(感觉神经末梢;仅一个小手指尖上,就存在超过3000个感受器),它们不仅能够同时感知多种信号,还与成千上万个神经和神经元精密连通,使信号能够快速传递至大脑并迅速反应。生物体通过“生长”而非“组装”来解决传感器、执行器和神经网络之间的链接问题。如果要以人造方式组装出同等复杂的系统,所需的技术与工艺目前仍难以实现。
为了突破这一技术瓶颈,科学家们想到了一个折中的办法——将生命体与机器人融合,打造生物混合机器人(biohybrid robot)。这类机器人结合了生物系统的高效能量转换、强适应性、自我修复、环境交互等优势,以及机电系统的高精度控制、复杂任务执行与可批量制造等特点,是机器人技术发展的新方向。
最近,国际顶尖期刊Science Robotics发表了一项来自美国康奈尔大学的研究。该团队利用杏鲍菇的菌丝体,成功控制了两款不同形态的机器人运动,为“碳基-硅基”融合及生物-电子混合技术开辟了新路径。

杏鲍菇丨图源:参考文献[1]
为何偏偏选蘑菇?
平时用来烫火锅的蘑菇竟然能够操控机器人?这听起来像是天方夜谭,背后却大有文章。
生物混合机器人需满足三个条件:由生物组件与非生物组件融合构成;具备传感器、处理器与执行器等基本功能单元;拥有自主或半自主的环境交互能力。
目前这类机器人多使用动物细胞(或组织)作为控制单元,但动物细胞培养难度大、成本高、维护复杂。于是,科学家将目光转向非动物系统,却面临新的挑战:细菌生命周期太短,植物反应又太慢——如同《指环王》中的树人,动一下可能要等半天。
而我们日常食用的蘑菇,其实只是真菌的“繁殖体”,它真正的“身体”是深藏于地下的菌丝体(mycelium)。这些肉眼几乎看不见的菌丝,拥有惊人的生存能力:无论是极寒的北极冻土,还是存在核辐射的区域,它们都能顽强生长。更神奇的是,菌丝网络具备传感、通信、传输养分的功能,能快速产生和传递电信号。

肉眼看到的菌丝体(左)和电子显微镜观察下的菌丝体(右)丨图源:wikipedia
相较于动物和植物,菌丝体只需要少量水分和简单的营养就可实现长时间生存。而且,在自然界中一些真菌本身就寄生在特定的昆虫或植物体内,通过产生电信号和化学激素来影响宿主的行为,简直是为生物机器人量身定做的“天然控制器”!

麦角菌科的一些真菌可以通过寄生在昆虫身上来控制宿主的行为丨图源:参考文献[1]
如何让蘑菇指挥机器人?
要实现真菌控制机器人并不简单。这是一个结合了机械工程、电子学、真菌学、神经生物学和信号处理等多个领域的系统性工程。但想大概明白原理,就和把大象放进冰箱里一样简单。只需三步:
第一步,让蘑菇在机器人身上“安家”。科学家们用3D打印制作了一个特殊的支架,上面布满了微小的电极,就像给蘑菇准备了一张“信号接收网”。然后,他们把杏鲍菇的菌丝体接种在支架上,让菌丝慢慢生长逐渐包裹住电极,这个过程大约需要2到4周。而之所以选择杏鲍菇作为研究对象,是因其菌丝生长模式简单、生长速度快并且安全无毒。
在支架上培养杏鲍菇菌丝丨图源:参考文献[4]

菌丝体包裹电极丨图源:参考文献[4]
第二步,偷听蘑菇的“悄悄话”。菌丝体感知环境时,会产生微弱的电信号,有点像我们大脑里神经元传递信息的“动作电位”。这些信号非常微弱,比一节干电池的电压还要小几千倍。所以科学家们给支架加了“防干扰护盾”(法拉第笼),隔绝外界的电磁干扰,再用高灵敏度的设备记录这些电信号的变化。比如,当紫外线照射到菌丝体时,它会发出更强烈的电信号,仿佛在喊:“好刺眼,快躲开”!

记录杏鲍菇产生的电信号图源:参考文献[4]
第三步,把“蘑菇语”翻译成“机器人语”。在大多数动物的大脑中,有一个被称为“中枢模式发生器”(Central pattern generator,CPG)的系统,这个系统就像生物的“内置节拍器”,能让我们不用刻意控制就能走路、呼吸。科学家模仿动物大脑里的CPG设计了一套算法。这套算法能识别菌丝体电信号的节奏和强度,把它们转换成数字指令,比如“前进”“转弯”“加速”。信号增强,机器人就加速;节奏改变,机器人则调整步态,就像我们根据路况改变走路方式一样。

机器人的动力系统接收蘑菇的数字指令(左)从而形成运动(右)图源:参考文献[4]
蘑菇机器人究竟能干啥?
基于上述三步,研究团队设计了两款超酷的真菌机器人。
第一款是“海星机器人”,身体由柔软的硅胶做成,靠充气“腿”伸缩移动,菌丝体支架装在它的背上。当菌丝体发出自然的电信号时,机器人会慢慢收缩“腿”,像海星在海底爬行一样,一步一步往前挪;当用紫外线照射菌丝体时,电信号变强,它的“步伐”会加快,仿佛在躲避强光。

使用紫外线照射时蘑菇机器人的动作频率显著加快丨图源:参考文献[4]
第二款是四轮迷你越野车,自带电池和信号处理器,能独立工作。当菌丝体感知到环境中的化学物质时,电信号会引导机器人调整方向,比如朝着化学物质浓度低的地方移动。研究人员还发现,只要定期给菌丝体补充营养液和孢子,它就能持续“工作”,甚至在旧的菌丝体老化后,新的菌丝体还能继续生长,实现“自我更新”!

使用紫外线照射时,杏鲍菇会发出指令让小车加速前进图源:参考文献[4]
尽管这两款蘑菇机器人还很“简单”,其潜力却十分可观!我们可以展望一下未来。
在农业领域,菌丝体对土壤里的化肥残留、重金属、病虫害极为敏感。未来,带着菌丝体传感器的机器人可以在农田里巡逻,一旦发现土壤酸碱度失衡,或者出现有害病菌,就会立刻发送信号,提醒农民调整施肥量,或者精准喷洒农药,减少污染。
在极端环境探测中,菌丝体不怕辐射、耐严寒、耐盐碱,蘑菇机器人可以代替人类去危险的地方执行任务:比如检测核污染区域的辐射水平,或者在极地冰原探测气候变化。
甚至在太空探索中,它们也能发挥作用,只需要携带少量菌丝体孢子,到了火星或月球后,让菌丝体在当地的支架上生长,就能造出“就地取材”的探测机器人,大大降低太空任务的成本。
也许,在不远的将来,帮助你驾驶机甲去捍卫和平的,不止有AI,还有蘑菇......
小 结
蘑菇机器人的研发,给我们带来了一个有趣的启示:科技未必总是冷冰冰的芯片和机械,它也可以与自然和谐共生。在普通人眼中,科学家只是换了一种方式控制机器人。但实际上,他们搭建起环境信号、机器人与生命系统之间的桥梁,将不可见的信号转化为真实的物理动作。
这恰恰证明:“创新”不一定需要追逐遥不可及的“黑科技”。有时候,低下头看看脚下的泥土、留意身边的植物,或许就能找到突破的灵感。
致谢:
感谢中国科学院大学尚雪副教授、陕西省微生物研究所孙超副研究员、中国科学院西安分院王长晔老师及广东科技出版社李旻老师等友人为撰写本文提供的文献、图片资料和宝贵意见。
参考文献
[1] OliviaFerrari. Watchthisfunguscontrolarobot. National Geographic, 2024, 0829
[2] 石晓军等. 2024年仿生智能技术综述. 无人系统技术, 2025, 08(01): 117-124
[3] 杨宁. 有细胞组织的生物混合机器人. 科学大观园, 2016, 18
[4] Anand Kumar Mishra et al. Sensorimotor control of robots mediated by electrophysiological measurements of fungal mycelia. Science Robotics, 2024, 09: 1-14
[5] Xianhong Zhang,et al. Common mycorrhizal networks facilitate plant disease resistance by altering rhizosphere microbiome assembly. Cell Host & Microbe, 2025, 33:1–14
[6] Andrea Genreet al. Unique and common traits in mycorrhizal symbioses. Nature Reviews Microbiology, 2020,18,649-660.
[7] Central pattern generator - Wikipedia

特 别 提 示
1. 进入『返朴』微信公众号底部菜单“精品专栏“,可查阅不同主题系列科普文章。
2. 『返朴』提供按月检索文章功能。关注公众号,回复四位数组成的年份+月份,如“1903”,可获取2019年3月的文章索引,以此类推。
版权说明:欢迎个人转发,任何形式的媒体或机构未经授权,不得转载和摘编。转载授权请在「返朴」微信公众号内联系后台。
来源: 返朴
内容资源由项目单位提供
科普中国公众号
科普中国微博

帮助
返朴 